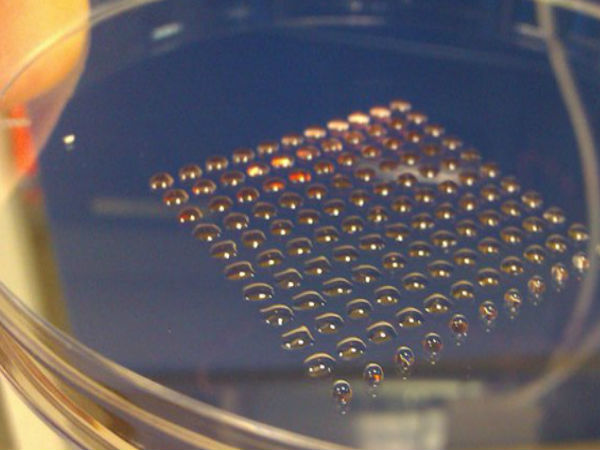
3డీ ప్రింటింగ్‌తో అద్భుతాలు

3డీ ప్రింటింగ్తో అద్భుతాలు
2013లో ప్రారంభమైన 3డీ ప్రింటర్ల హవా అన్ని విభాగాల్లోనూ విస్తరించింది. ఇంజనీరింగ్, క్లాతింగ్ ఇలా అనేక పరిశ్రమల్లో 3డీ ప్రింటర్లను విస్తృతంగా వాడుతున్నారు. మనకు కావల్సిన మెటీరియల్తో మనకు నచ్చిన వస్తువులను ఈ 3డీ ప్రింటర్ల ద్వారా తయారు చేసుకోవచ్చు.2015లో 3డీ ప్రింటర్ల వినియోగం మరింతగా పెరిగిపోయింది. 3డీ ప్రింటర్లతో పెద్దపెద్ద విల్లాలనే నిర్మించేస్తున్నాయి. 3డీ ప్రింటింగ్ ద్వారా క్రియేట్ చేయబడిన 10 ఆసాధారణ వస్తువులను ఇప్పుడు చూద్దాం...

3డీ ప్రింటింగ్తో అద్భుతాలు
3డీ ప్రింటింగ్తో అభివృద్థి చేయబడిన మెచీన్ గన్

3డీ ప్రింటింగ్తో అద్భుతాలు
3డీ ప్రింటింగ్తో అభివృద్థి చేయబడిన బయోనిక్ ఇయర్

3డీ ప్రింటింగ్తో అద్భుతాలు
3డ్రీ ప్రింటెడ్ బ్రా

3డీ ప్రింటింగ్తో అద్భుతాలు
3డీ ప్రింటింగ్ ద్వారా అభివృద్థి చేయబడి ముఖం

3డీ ప్రింటింగ్తో అద్భుతాలు
3డీ ప్రింటింగ్ ద్వారా అభివృద్థి చేయబడిన మనిషి పుర్రె

3డీ ప్రింటింగ్తో అద్భుతాలు
3డీ ప్రింటింగ్ ద్వారా అభివృద్థి చేయబడిన పిండం

3డీ ప్రింటింగ్తో అద్భుతాలు
3డీ ప్రింటింగ్ ద్వారా అభివృద్థి చేయబడిన ఆహారం

3డీ ప్రింటింగ్తో అద్భుతాలు
3డీ ప్రింటింగ్ ద్వారా అభివృద్థి చేయబడిన మనిషి పుర్రె
3డీ ప్రింటింగ్తో అద్భుతాలు
3డీ ప్రింటింగ్ ద్వారా అభివృద్ధి చేయబడిన స్టెమ్ సెల్స్

3డీ ప్రింటింగ్తో అద్భుతాలు
3డీ ప్రింటింగ్ ద్వారా అభివృద్థి చేయబడిన హెయిర్ స్టైల్

3డీ ప్రింటింగ్తో అద్భుతాలు
3డీ ప్రింటింగ్ ద్వారా అభివృద్థి చేయబడిన వైలిన్


Click it and Unblock the Notifications